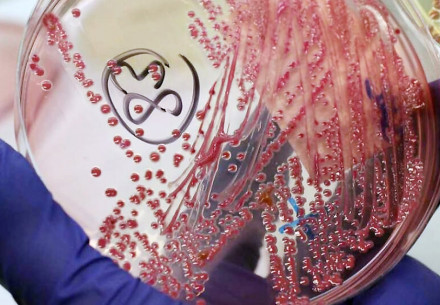

Завідувач відділу власних кореспондентів журналу «Охорона праці». Журналіст, фоторепортер, спеціальний кореспондент.
Знання, досвід і компетенції
- Понад 30 років досвіду в журналістиці.
- Має вищу фахову освіту: факультет журналістики Київського державного університету ім. Т. Шевченка.
- Працював:
- на посаді заввідділу фотоілюстрацій у газеті «Вісник Переяславщини». Неодноразово виборював звання «Кращий журналіст року»;
- у всеукраїнських виданнях – газетах «Сегодня», «День», «Комсомольская правда в Украине»;
- під час роботи у департаменті маркетингу компанії «Єврокредит», ЗАТ «ФОРА», випускав корпоративні інформаційно-рекламні видання;
- менеджером з інформаційного забезпечення в компанії з інформаційних технологій «ІНКОМ».
- 10 років – у журналі «Охорона праці», спецкор і фоторепортер.